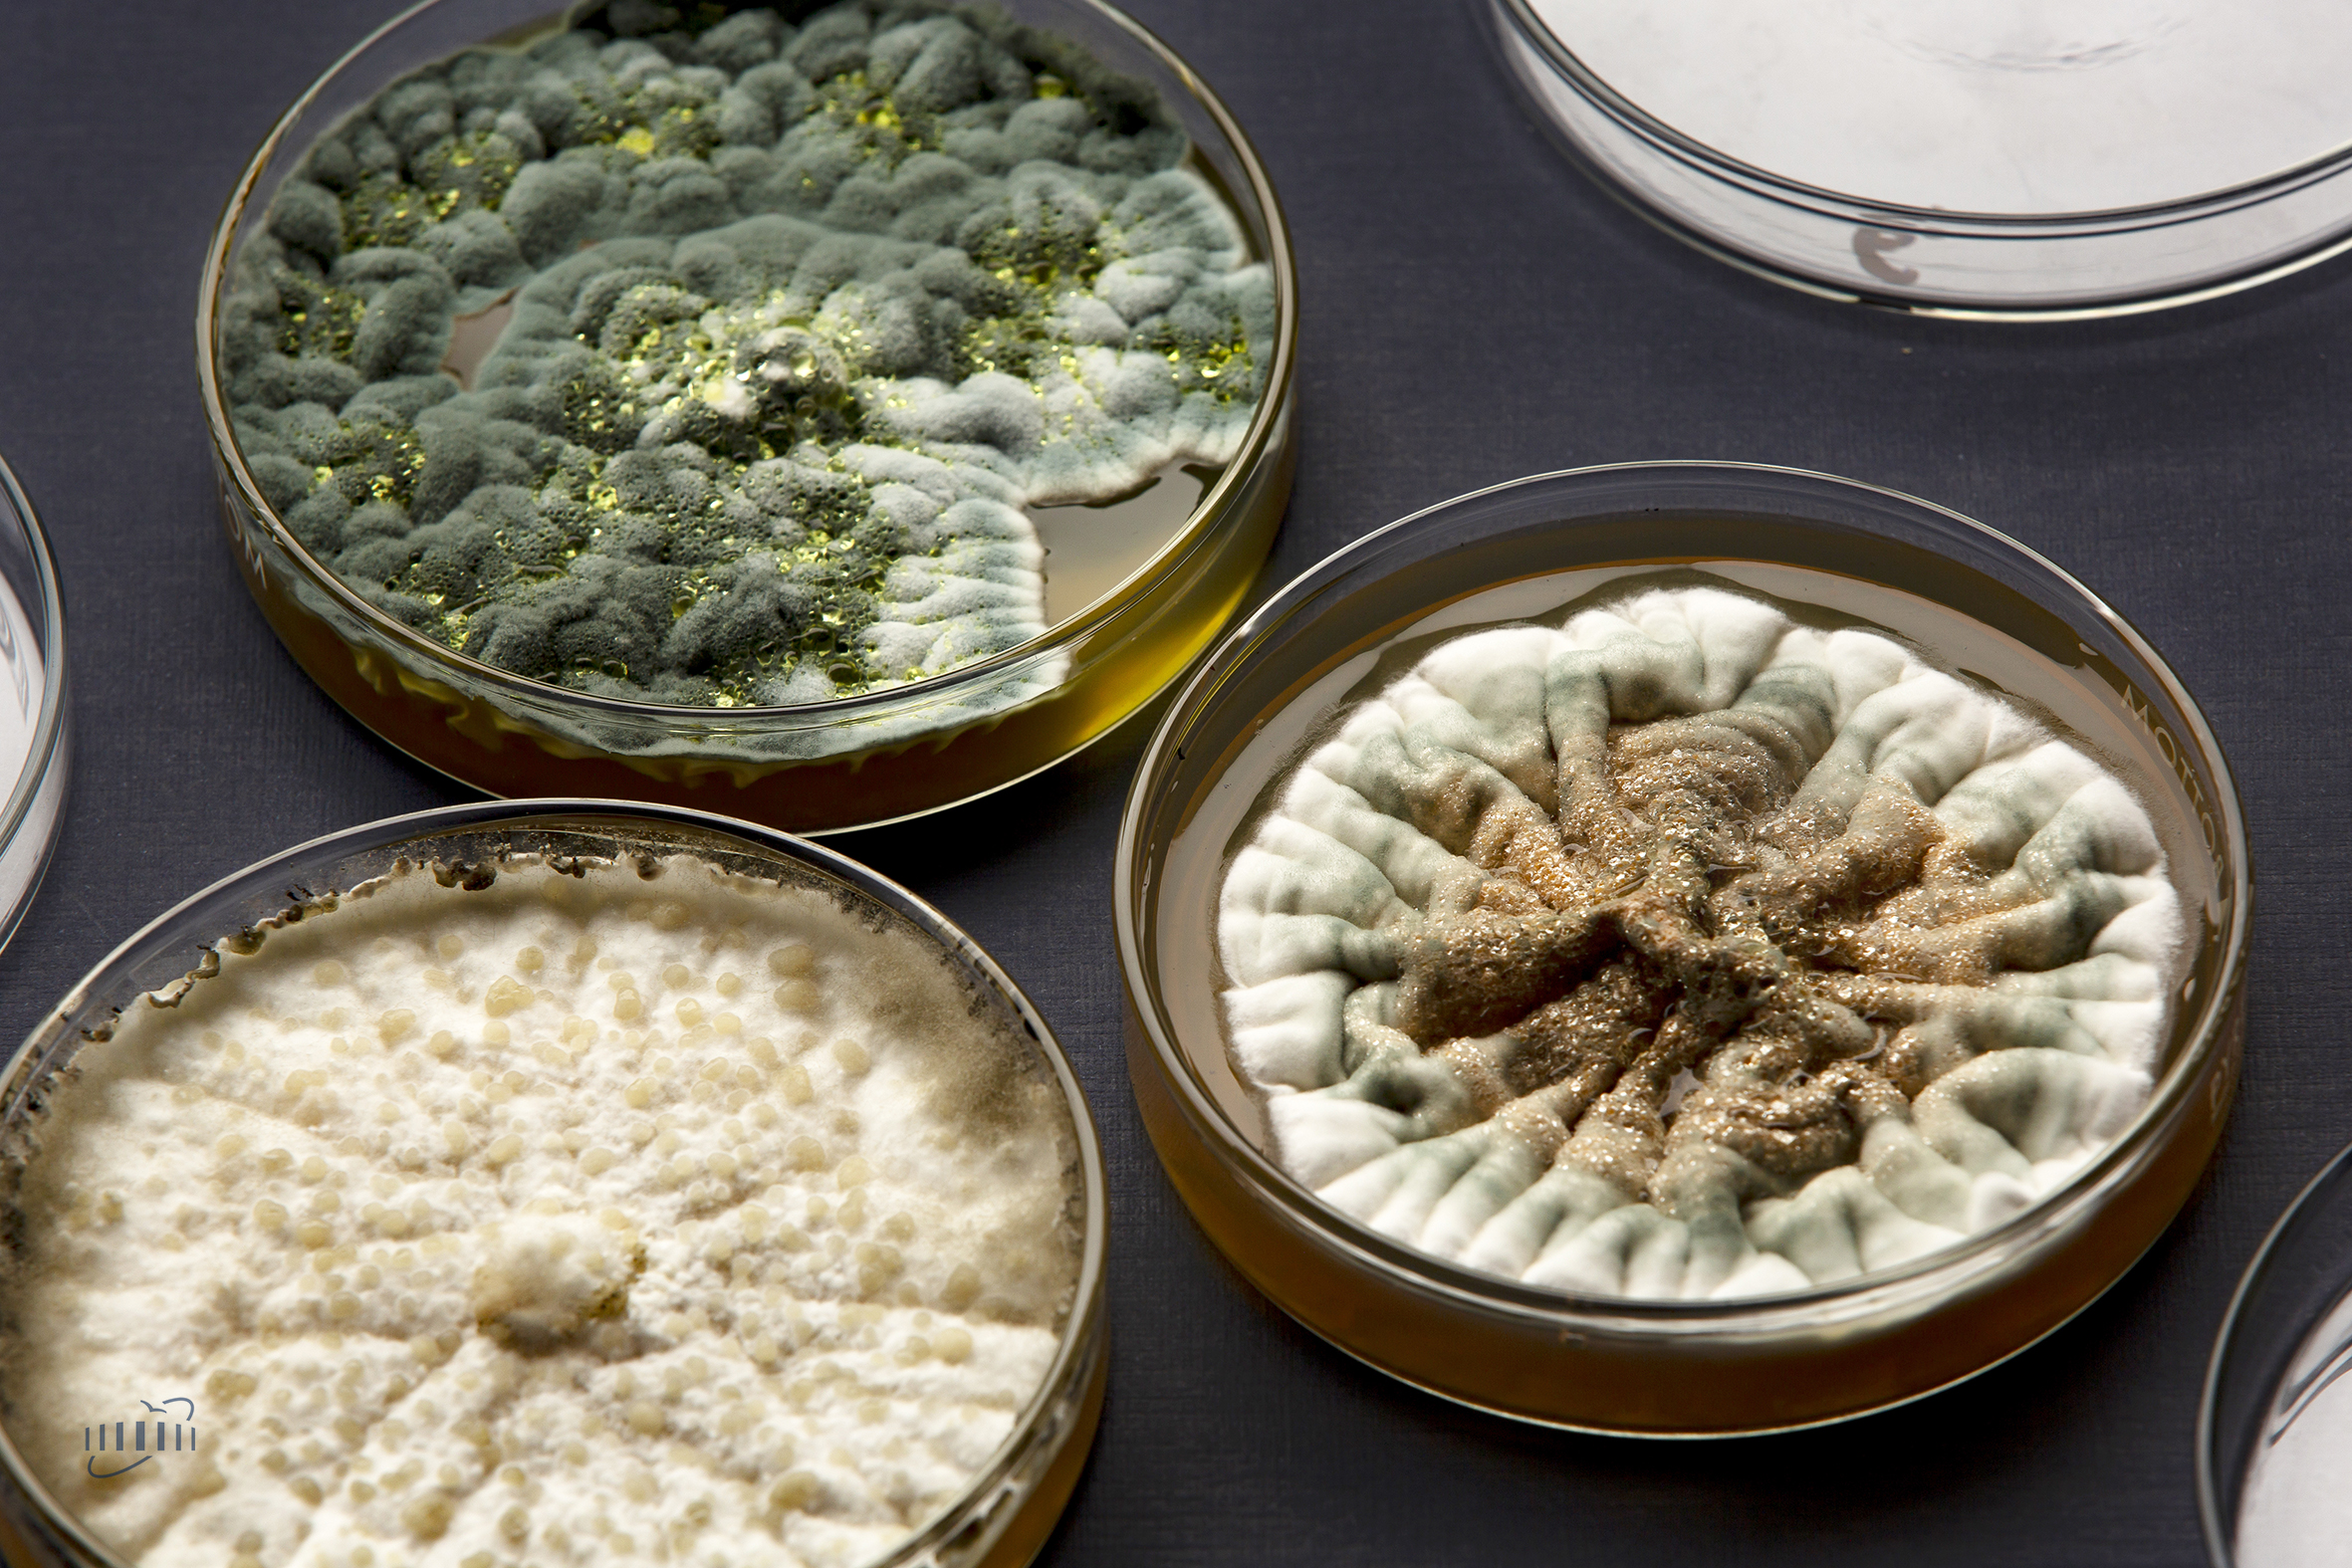
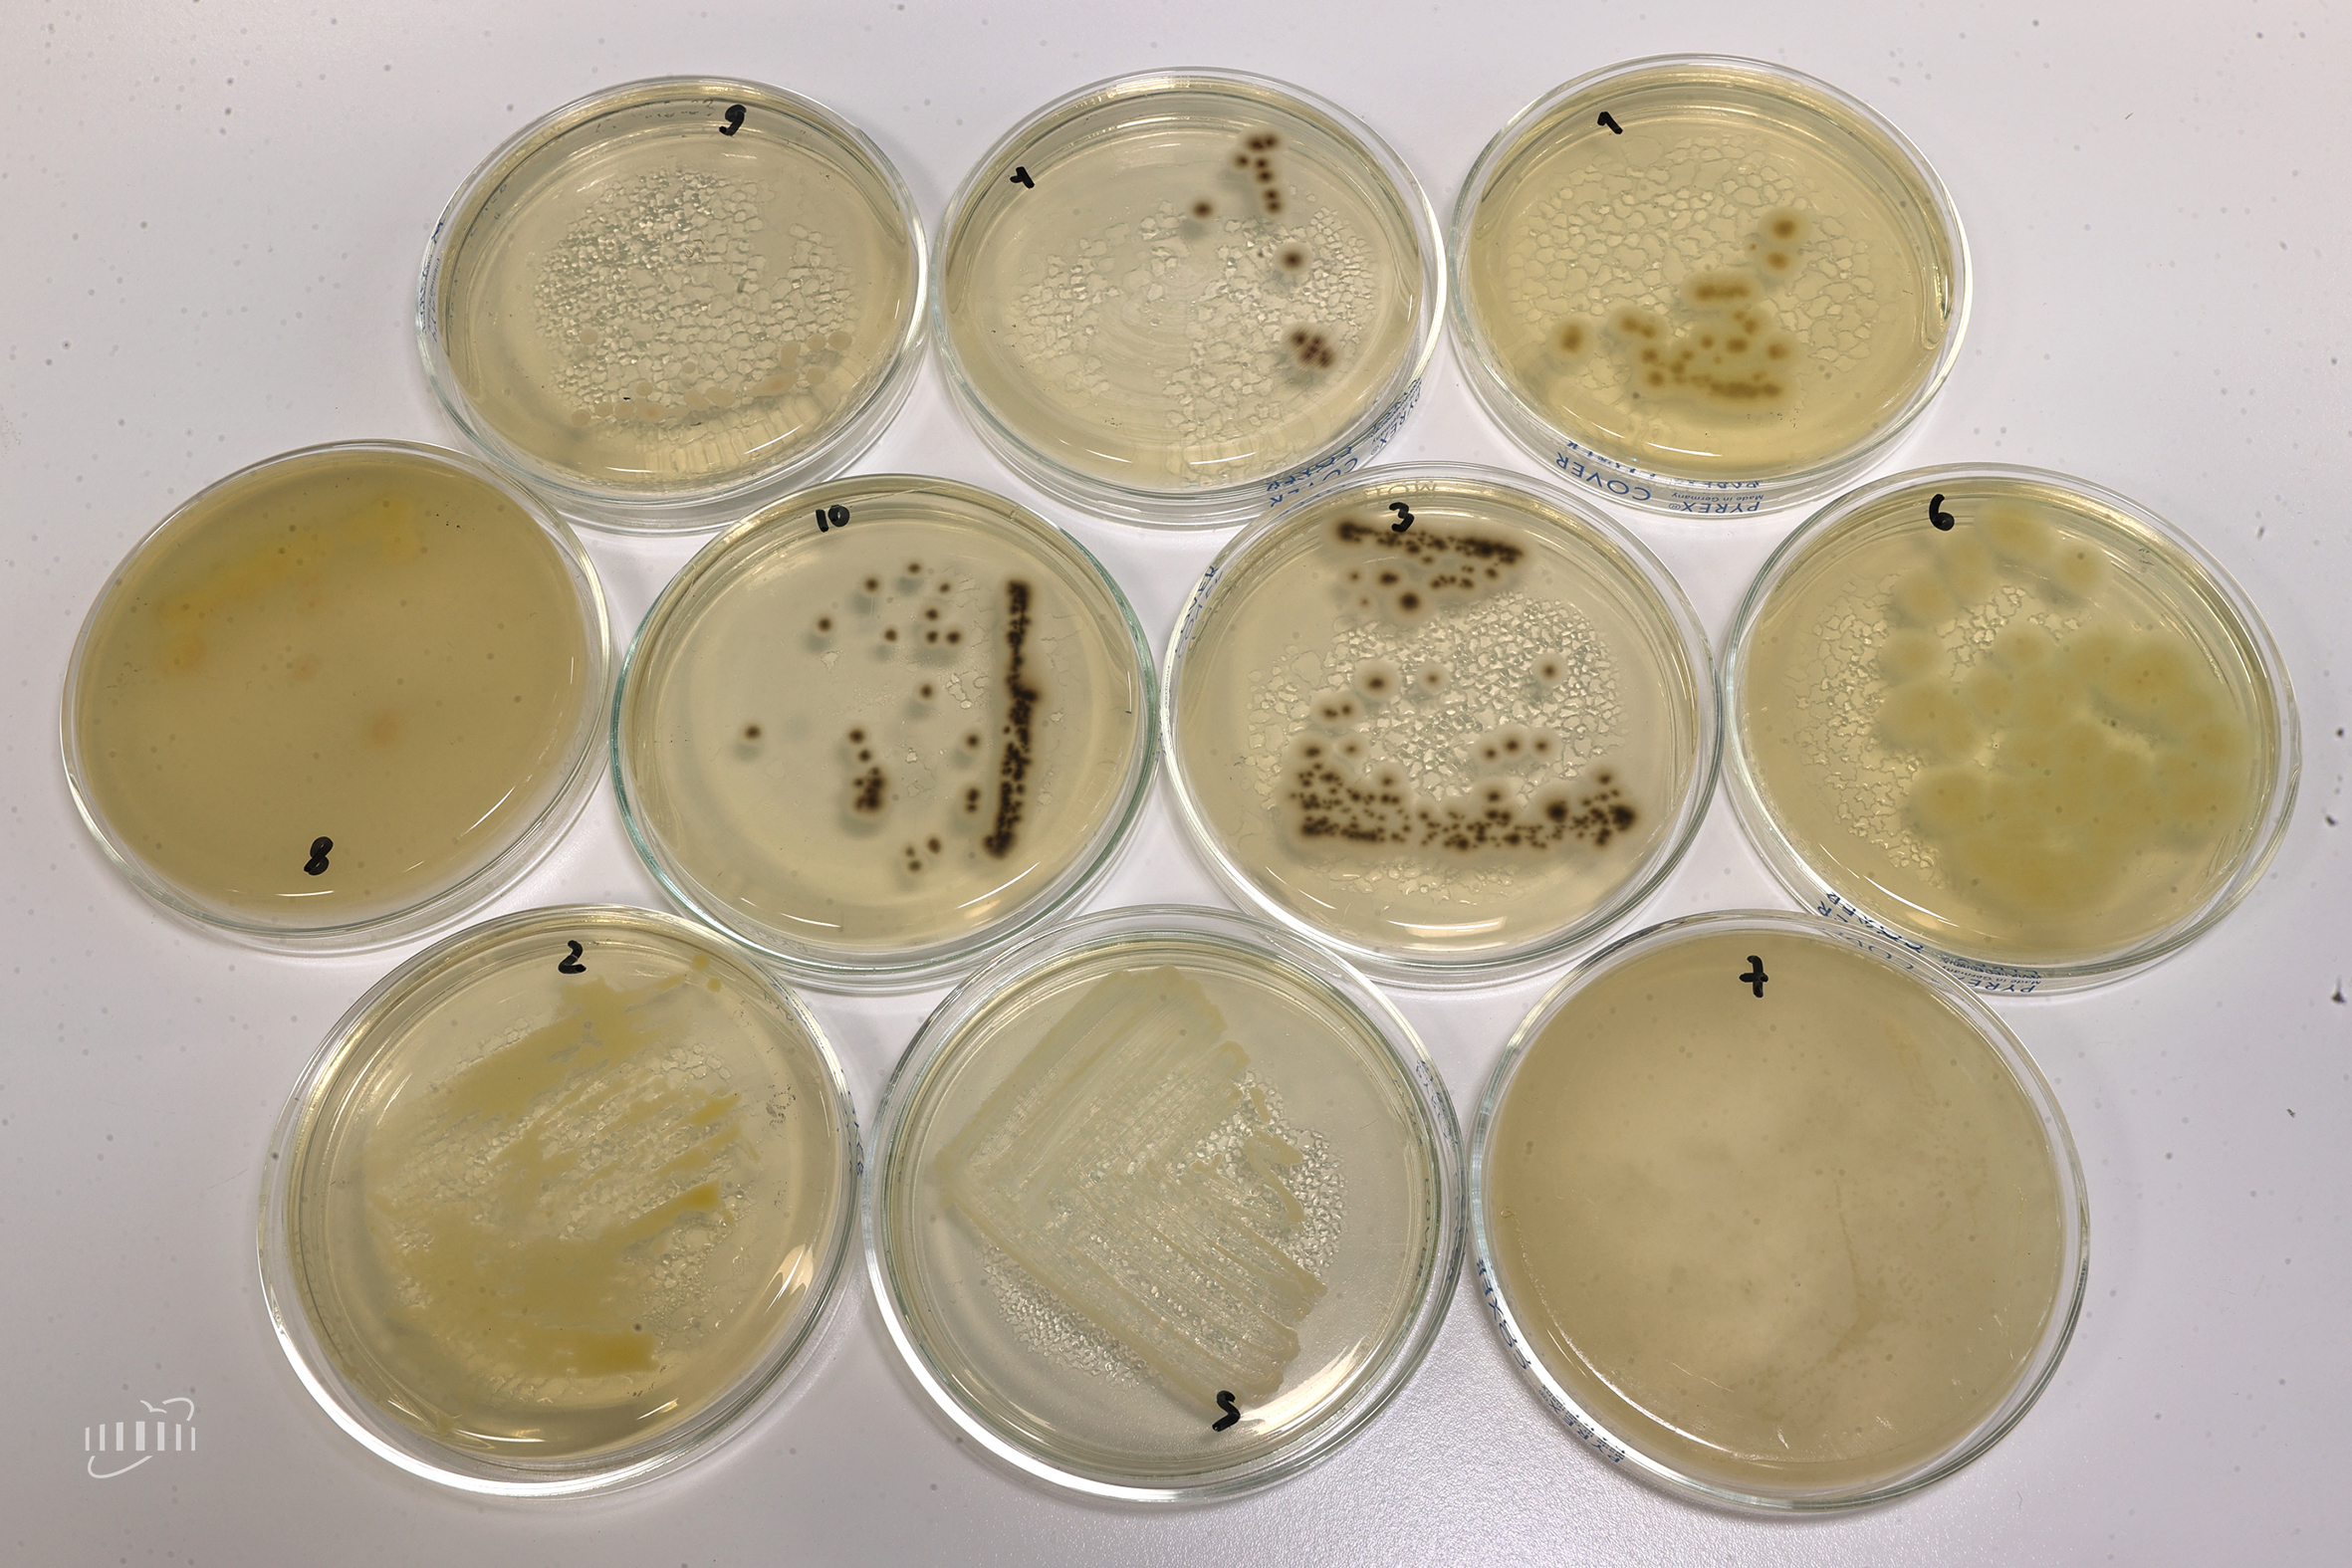

Ученые ОИЯИ обнаружили радиорезистентные грибы вблизи активной зоны реактора ИБР-2
Новости, 25 июня 2025
Ученые Сектора молекулярной генетики клетки Лаборатории ядерных проблем ОИЯИ обнаружили, что вблизи центра исследовательского реактора ИБР-2, при радиационном фоне за сутки, в 16 раз превышающем смертельную дозу радиации для человека, присутствуют живые организмы – грибы нескольких видов. Научная группа проводит исследование, посвященное тому, какие именно генетические механизмы позволили грибам приспособиться к выживанию в настолько суровых условиях. В дальнейшем будет проведен повторный поиск на реакторе представителей этого и других царств живой природы. Исследование уникально тем, что удалось разработать систему пробоотбора и произвести сбор образцов максимально близко к самому «сердцу» ядерного реактора и проверить, обитают ли там живые организмы.
Радиорезистентные грибы после нескольких месяцев роста в чашках Петри
Радиорезистентные грибы после нескольких месяцев роста в чашках Петри
В ЛЯП с 2019 года уже проводятся исследования экстремальной радиорезистентности самых устойчивых к физико-химическим стрессам животных – тихоходок. Дополнительно обратить внимание на поиск устойчивых к радиации организмов в зоне реактора ИБР-2 предложил директор ЛЯП Евгений Якушев. В отличие от ускорителей частиц, в зоне ИБР-2 значительный радиационный фон присутствует постоянно, поскольку там, даже при остановке реактора, непрерывно происходят распады ядерного топлива – диоксида плутония.
«Радиационный фон в зоне реактора ИБР-2 есть всегда: в этом году в неактивном состоянии реактора фон составлял около 160 Грей в сутки. Таких показателей нет нигде в природе. Для сравнения: для человека доза в 10 Грей смертельна», — рассказала начальник Сектора молекулярной генетики клетки ЛЯП ОИЯИ Елена Кравченко. В то же время на ИБР-2 есть возможность подобраться почти к самому центру реактора, где находятся топливные элементы. Туда подходят каналы различных исследовательских установок, при этом некоторые каналы находятся сразу за стенкой активной зоны реактора. Сотрудники Сектора нового источника и комплекса замедлителей Лаборатории нейтронной физики ОИЯИ предоставили коллегам из ЛЯП возможность отобрать биологические пробы из самой близкой к реактору области в канале № 3 ИБР-2, на котором тестируется на устойчивость к радиации электроника и различные материалы.
 Автоматический бокс для отбора проб
Автоматический бокс для отбора проб
Для пилотного эксперимента по отбору образцов начальник Сектора астрофизических исследований ЛЯП ОИЯИ Артур Бородин изготовил и запрограммировал автоматический бокс – герметичную коробочку, внутри которой находилась чашка Петри с питательной средой. Закрытый бокс, предварительно простерилизованный в лаборатории, был доставлен в дальнюю часть канала № 3. Достигнув ближайшей к реактору точки (менее полуметра от активной зоны), бокс автоматически открылся на 24 часа, затем вновь закрылся и был транспортирован обратно.
В отношении грибов и бактерий такой метод пробоотбора эффективен, так как их споры и клетки способны попасть в лабораторную емкость с питательной средой из воздуха в точке отбора. Чашки, побывавшие в зоне ИБР-2, были наполнены стерильной питательной средой, подходящей для роста и развития грибов определенных видов – генетики ЛЯП ОИЯИ решили начать исследование с более сложно устроенных, чем бактерии, организмов. Присутствие животных в исследуемом месте маловероятно, но теоретически в этих условиях могли бы выжить и тихоходки.
«К нашей радости, уже в первом эксперименте на чашке выросло семь видов грибов», — отметила Елена Кравченко. Грибы выросли практически сразу из активных, жизнеспособных клеток: буквально на следующие сутки у ученых уже имелись небольшие колонии. Попадая в нормальные условия из стрессовых, грибы с повышенной радиационной устойчивостью спокойно продолжают жить и размножаться. Важно отметить, что они являются непатогенными и опасности для человека не представляют.
Радиорезистентные грибы после отбора проб на ИБР-2
Радиорезистентные грибы после отбора проб на ИБР-2
«Мы разобрали их на отдельных представителей, сделали простую видовую идентификацию с помощью секвенирования маленького кусочка гена, кодирующего 18S РНК, и узнали, что из ИБР-2 к нам попали пенициллы, ауреобазидиум, пиронема и другие. Затем мы сделали полногеномное секвенирование пока одного из семи видов – прочитали и собрали весь его геном. Сейчас идет анализ, мы встраиваем отсеквенированный вид в филогенетическое дерево всех живых организмов. Если он ни с чем не совпадет, – возможно, это новый вид», — сообщила Елена Кравченко.
Основная проблема, которую решают сотрудники Сектора молекулярной генетики клетки, – каким образом живой организм приспосабливается к экстремально высоким дозам радиации? Для этого необходимо определить, какие гены и каким образом расположены в геноме. После того, как гены в геноме грибов будут размечены, ученые проведут эксперименты со всеми обнаруженными видами: контрольная чашка Петри с определенным видом будет находиться при нормальном радиационном фоне, другая же чашка будет облучена высокими дозами радиации. Затем генетики выделят РНК из клеток грибов с контрольных и облученных чашек и проанализируют, какие гены активируются в ответ на действие радиации.
«Зная, какие гены ответили, мы сможем сказать, какие механизмы адаптации смог выработать организм в ходе естественного отбора и суровых условий существования: например, он очень хорошо репарирует свою ДНК либо у него есть системы, которые защищают ДНК», — пояснила Елена Кравченко. Также в дальнейших планах ученых — отправить в зону реактора ИБР-2 чашки Петри с питательными средами для других организмов до и после запуска реактора.
Такие исследования, отмечает Елена Кравченко, помимо их фундаментальной научной важности, будут полезны в будущем для планирования дальних пилотируемых космических полетов, например, станет возможным модифицировать сельскохозяйственные культуры с тем, чтобы выращивать их прямо на космическом корабле во время полета. Также радиационно устойчивые организмы смогут помочь в очистке загрязненных радионуклидами территорий на Земле, а механизмы радиопротекции, разработанные ими, помогут для защиты здоровых тканей вокруг раковой опухоли при ее облучении.
 Начальник Сектора молекулярной генетики клетки ЛЯП ОИЯИ Елена Кравченко
Начальник Сектора молекулярной генетики клетки ЛЯП ОИЯИ Елена Кравченко
Исследования радиорезистентности грибов, найденных в зоне реактора ИБР-2, займут несколько лет работы у ученых сектора. Получаемые результаты станут уникальными, подобных экспериментов пока не проводилось нигде в мире, так как подобраться с исследовательским оборудованием так близко к центру ядерных распадов на атомной электростанции практически невозможно, а научная инфраструктрура ИБР-2 позволяет это сделать.
Повышенный радиационный фон в зоне ИБР-2 действовал на попавшие туда живые организмы годами, задолго до отбора проб, поэтому постоянное действие высокого радиационного фона позволило выжить только тем организмам, в геноме которых возникли уникальные наследуемые механизмы радиорезистентности и адаптации.
«Это удачное совпадение обстоятельств, установок, людей и целей, которое позволяет провести такое исследование только здесь, в ОИЯИ», — подытоживает Елена Кравченко.
«В местах радиационных аварий, таких как Фукусима или Чернобыль, активно исследуются экосистемы, сформировавшиеся годы спустя после аварии. Однако там, куда есть доступ у исследователей, фон на несколько порядков ниже, чем в зоне реактора ИБР-2. И уже сейчас можно сказать, что найденные там виды организмов иные, чем на ИБР-2», — отмечает младший научный сотрудник сектора Михаил Зарубин.
 Младший научный сотрудник Сектора молекулярной генетики клетки ЛЯП ОИЯИ Михаил Зарубин
Младший научный сотрудник Сектора молекулярной генетики клетки ЛЯП ОИЯИ Михаил Зарубин